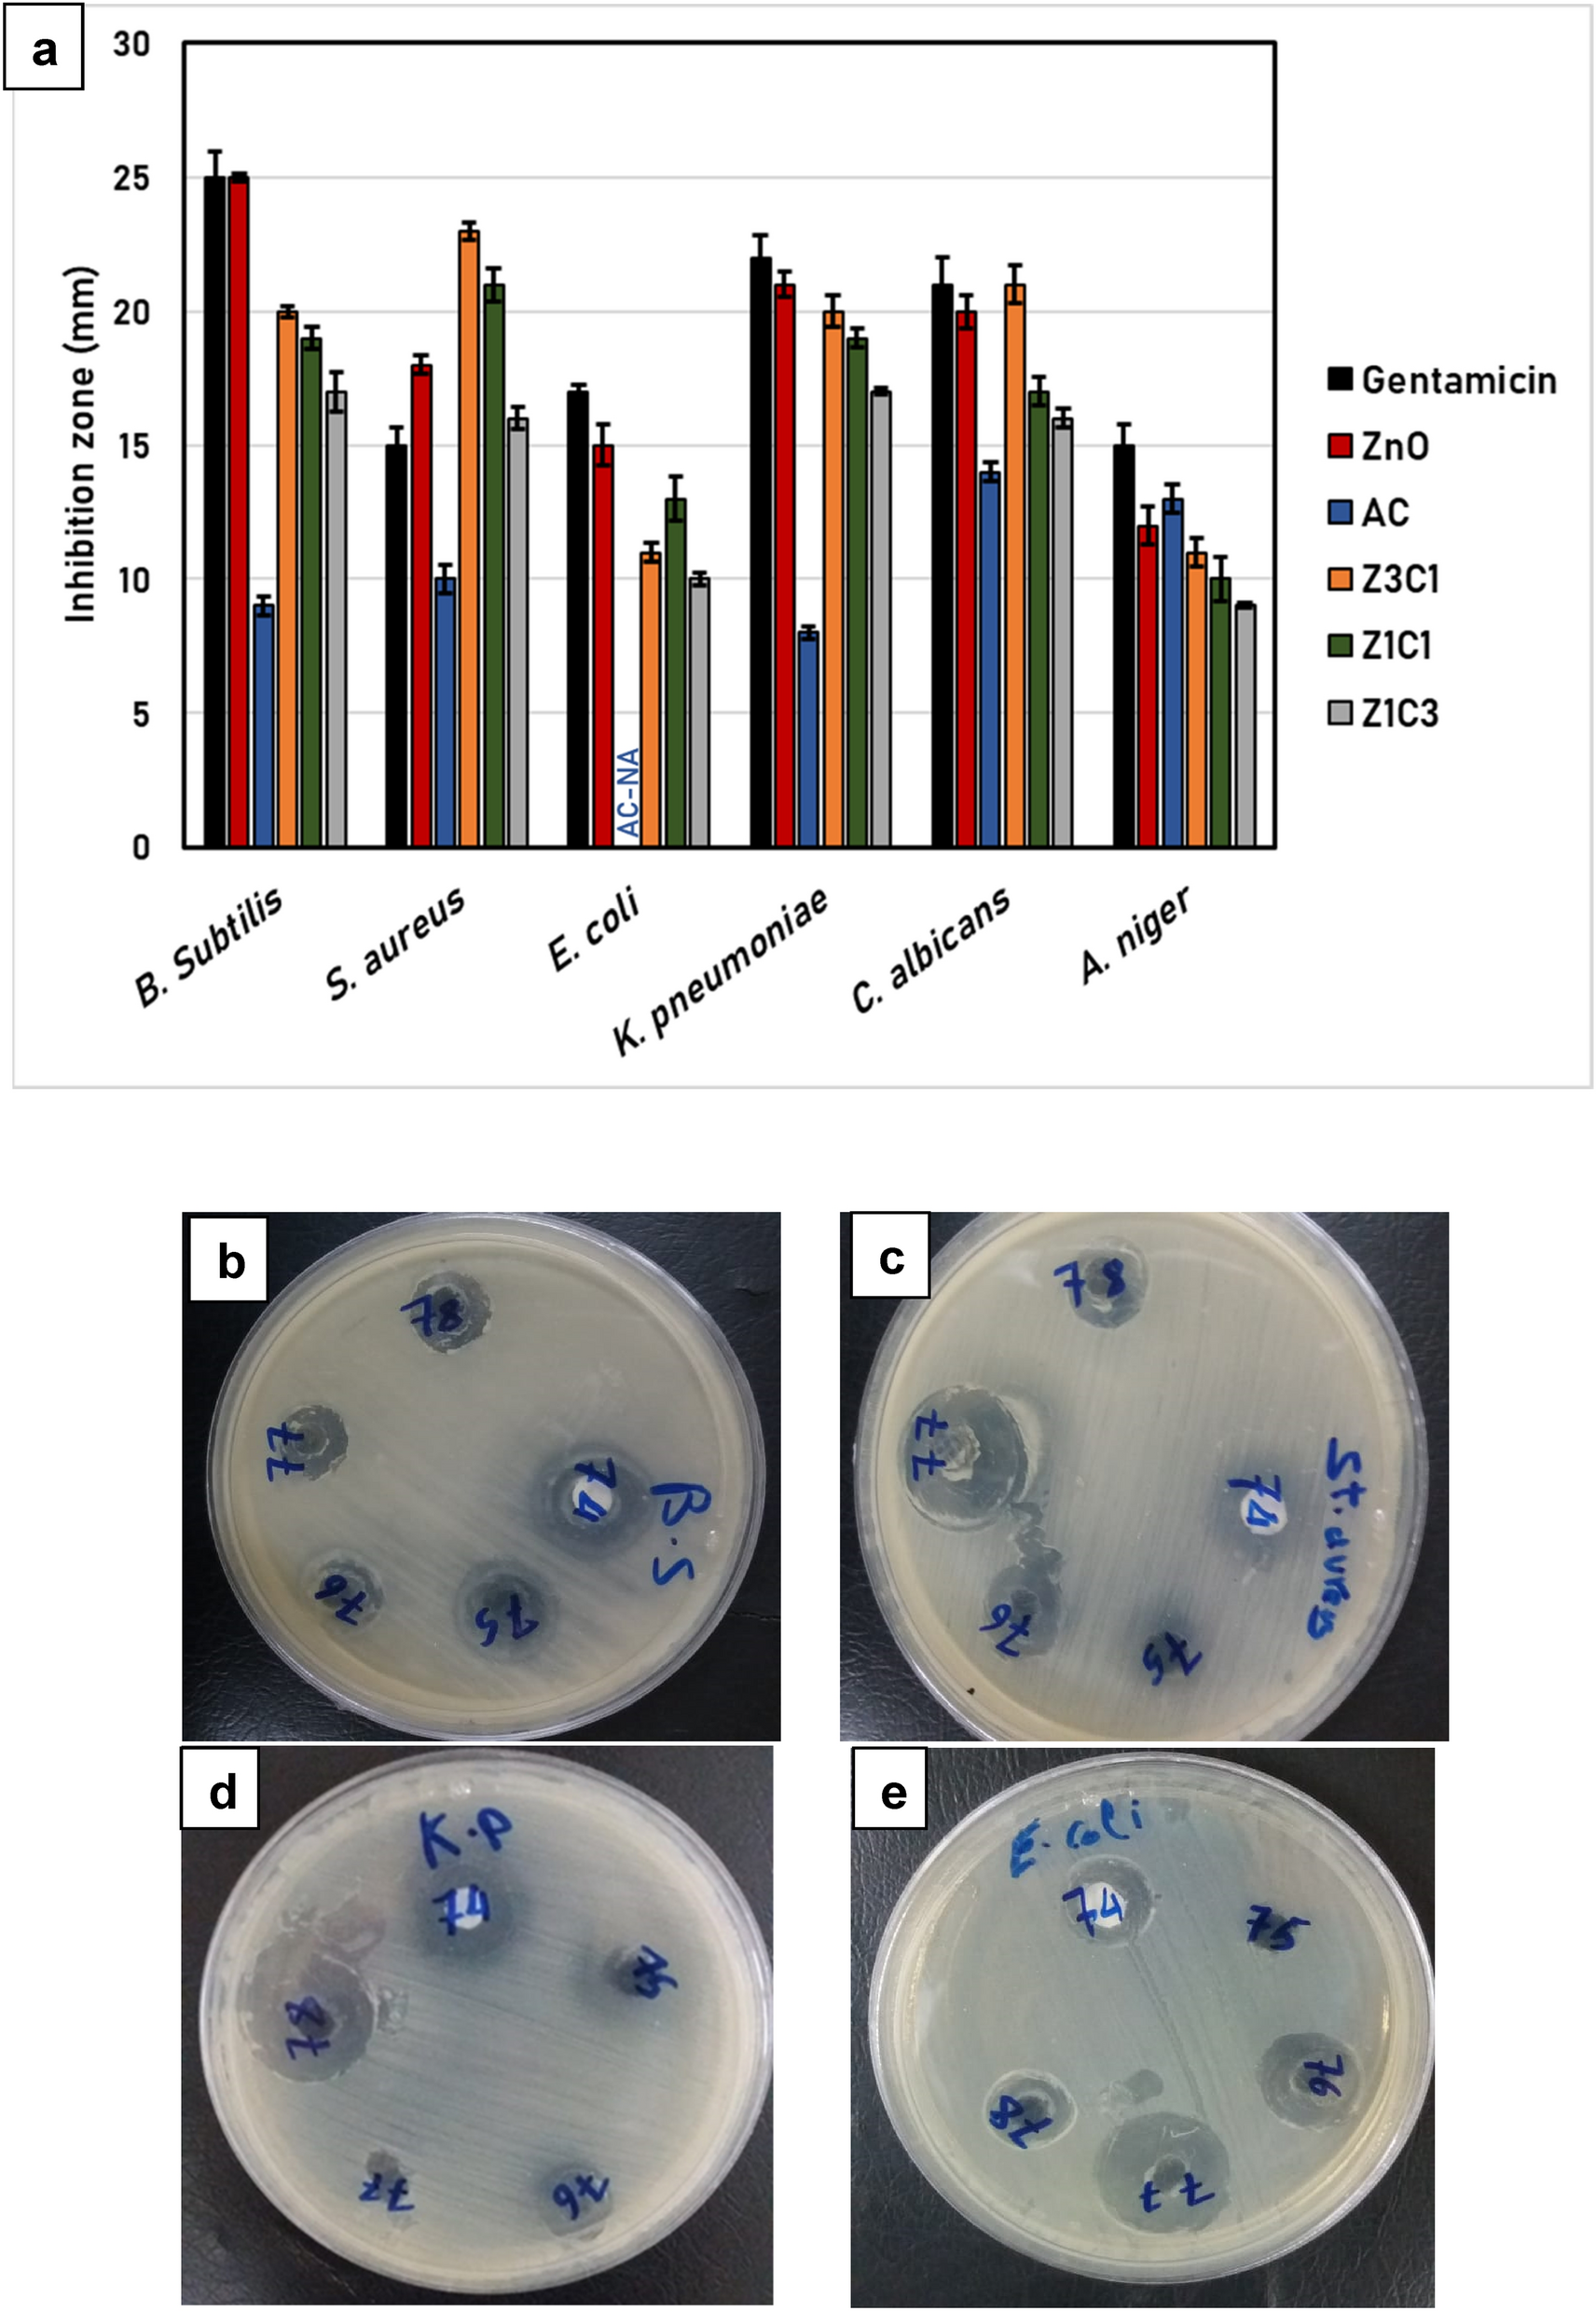
Figure 1

Figure 1
(a) Antimicrobial impact of the synthesized ZnO/AC nanocomposites against Gram-positive, Gram-negative bacteria, and unicellular and multicellular fungi. The values are the average of 3 replicates expressing the diameter of the clear zones (mm), while the error bars represent standard deviations. (NA): no activity; Samples for the antimicrobial impact of the synthesized nanocomposites against (b) Bacillus subtilis; (c) Staphylococcus aureus; (d) Klebsiella pneumonia; and (e) Escherichia coli. The codes of the wells are referring to the following: (74): neat ZnO NPs; (75): neat AC; (76): Z3C1; (77): Z1C1; (78): Z1C3.
